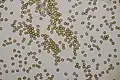
Sporen

Straatchampignon
| Straatchampignon | |||||||||||||||
|---|---|---|---|---|---|---|---|---|---|---|---|---|---|---|---|

| |||||||||||||||
| Taxonomische indeling | |||||||||||||||
| |||||||||||||||
| Soort | |||||||||||||||
| Agaricus bitorquis (Quél.) Sacc. (1887) | |||||||||||||||
| Afbeeldingen op | |||||||||||||||
| Straatchampignon op | |||||||||||||||
| |||||||||||||||
De straatchampignon (Agaricus bitorquis) is een schimmel uit de familie Agaricaceae. Hij heeft een stevige steel die is voorzien van een vliezige, dubbele ring. De soort is zeer nauw verwant met de gekweekte champignon (Agaricus bisporus) en de gewone weidechampignon (Agaricus campester). Hij is hiervan eenvoudig te onderscheiden door de dubbele ring. Hij groeit op de grond, voornamelijk in steden. Hij is te vinden in tuinen, langs bermen, in stadsparken en vlierbessenstruiken, soms in trottoirspleten en zelfs in oud, beschadigd pleisterwerk.
Kenmerken
Uiterlijke kenmerken
- Hoed
De hoed heeft een diameter van 4 tot 12 cm en bij jonge exemplaren is deze bolvormig, maar later wordt deze vlak gewelfd. De huid is glad, vlezig en droog en vaak niet vrij van zand. De kleur is vuilwit met soms wat gelige of bruine vlekken.
- Lamellen
De plaatjes staan dicht bijeen en vrij van de steel. Hun kleur is eerst rozerood en later dof donkerbruin. De snede ervan is wat bleker en door een loep gezien hakkelig.
- Steel
De steel van de nogal plompe straatchampignon is korter dan de diameter van de hoed en heeft een dikte van 6 tot 12 mm en is 2 tot 3 cm hoog.[1] De basis is soms wat gezwollen. De steel is wittig, droog en glad of fijn vezelig. Er is een dubbele ring waarvan de bovenrand meer van de steel afstaat dan de onderrand.
- Vlees
Het vlees is hard en zeer compact, wit en verkleurt niet bij beschadiging of wordt licht roze.
- Sporenprint
De sporenprint is donkerbruin.
- Geur en smaak
Hij heeft een aangename amandelgeur en een nootachtige smaak.
Microscopische kenmerken
De sporen zijn elliptisch, glad en 5 tot 6,5 μm lang en 4 tot 5 μm breed. De basidia zijn meestal 4-sporig soms 2-sporig en meten 20–25 x 6,5–8,5 μm. De cheilocystidia zijn aanwezig maar onopvallend.
Verspreiding
De soort is een bewoner van voedselrijke, bemeste bodems. Hij komt voor in wegbermen, plantsoenen, tuinen, straten en stoepen, soms zelfs in gaten van het asfalt.[1] Het vruchtlichaam is in staat stoeptegels en asfalt opzij te drukken.[2] De soort is in Nederland en België algemeen[3] en kan daar worden waargenomen in de maanden mei t/m oktober.
Eetbaarheid
De paddenstoel is eetbaar, maar wordt minder vaak gegeten dan de gekweekte champignon. Dit komt doordat de vindplaats vaak verontreinigd is met uitlaatgassen of urine van honden.
Afbeeldingen
-
 Straatchampignon doorbreekt het asfalt
Straatchampignon doorbreekt het asfalt -
 Lamellen
Lamellen -
 Stevige voet met dubbele ring
Stevige voet met dubbele ring -
 Doorsnede met rossig vlees
Doorsnede met rossig vlees -
Sporen
Sporen -
 Basidia
Basidia
- Info op Flora Europa
- Dam en Kuyper (2013), Veldgids Paddenstoelen 1, KNNV Uitgeverij, Zeist
- ↑ a b Basisgids Flora En Fauna In Nederland. Tirion (1997), p. 370. ISBN 9070099365.
- ↑ Haas, H., Honders, H. & Paetzold, W. (1982). Paddestoelen van West- en Midden-Europa. Amsterdam: The Reader's Digest NV. ISBN 9064070725
- ↑ NMV Verspreidingsatlas Paddenstoelen